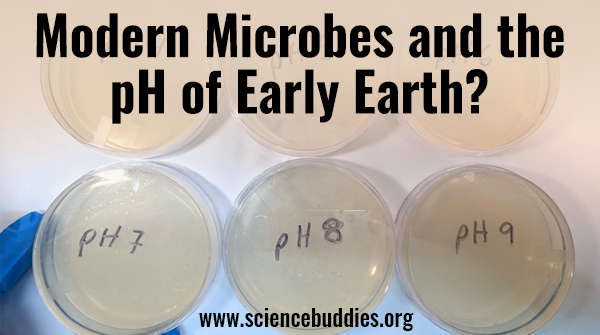
ScienceBuddies's tweet image. Can you find microbes today that could have survived the different pH conditions of the early Earth&apos;s oceans? Explore with this astrobiology project.

sbgo.org/modernmicrobes…

#STEM #scienceproject #spacescience #microbiology #scichat

#scienceproject ผลการค้นหา
With a Kimchi Chemistry project from Science Buddies, these middle school students turned an interest in food science into a flavorful exploration of chemistry and fermentation for the STEM Fair. sbgo.org/ss-kimchi25-tw #sciencefair #scienceproject #scienceteacher

Can you find microbes today that could have survived the different pH conditions of the early Earth's oceans? Explore with this astrobiology project. sbgo.org/modernmicrobes… #STEM #scienceproject #spacescience #microbiology #scichat

Are you working with Arduino and running into a problem? This Arduino Troubleshooting Guide helps students troubleshoot #STEM projects with #arduino. sbgo.org/arduinotrouble… #scienceproject #sciencefair #scienceteacher

How is your focus? Learn more about the Wisconsin Card Sorting Test & experiment to see if something as simple as "standing" makes a difference in executive function. Project: sbgo.org/focus25-tw #Neurodiversity #CognitiveScience #scienceproject #sciencefair #scienceteacher

Slaying the #scienceproject game with #MusicalGlasses, explained here by Harris V. And for all you @espn fans, see if you can recognize the song Harris plays using different volumes of water to impact pitch, which he measured using an app on his phone! 🤗


Inspire student curiosity with “color”-focused #STEM projects, from chemical reactions to color separation, biotechnology, plant science, and the physics of light. sbgo.org/color25-tw #scienceproject #scienceteacher #sciencefair

Ahh, Sunrun you never disappoint. How to turn NEGATIVE FCF of $(1,050)M in the 4Q into positive “Cash Generation” of $34M! $RUN #ScienceProject



What happens when a collision in space leads to a chain reaction of more collisions? Student #STEM project: “Simulating The Kessler Syndrome: How Satellite Collisions Could Spiral Out of Control.” sbgo.org/kessler25-tw #worldspaceweek #scienceproject #scienceteacher #scichat

November is #DiabetesAwarenessMonth - Students can explore the science behind blood glucose, insulin, and biomedical innovation with hands-on #STEM projects that connect biology, health, and engineering. sbgo.org/diabetes25-tw #scienceproject #scienceteacher #sciencefair

What microbes that exist today could have survived the pH conditions of early Earth? Investigate with microorganisms from a local water source in this student #microbiology project. sbgo.org/modernmicrobes… #STEM #scienceproject #spacescience #scienceteacher

Fifth grade students make their own first aid kit to finish the Science project about Health Habits and First Aid. 🚑 #HealthHabits #FirstAid #ScienceProject #escucha @feye_enred



𝐒𝐜𝐢𝐞𝐧𝐜𝐞 𝐄𝐱𝐡𝐢𝐛𝐢𝐭𝐢𝐨𝐧 𝐡𝐨𝐬𝐭𝐞𝐝 𝐛𝐲 𝐜𝐥𝐮𝐬𝐭𝐞𝐫 𝐄𝐚𝐬𝐭 𝐚𝐧𝐝 𝐖𝐞𝐬𝐭. #ScienceExhibition #scienceproject #schoolactivities #BaithakSchoolNetwork #SupportBaithakSchools




New student #AI #STEM project: Use the Prophet machine learning model to predict areas of wildfire susceptibility and intensity. Directions: sbgo.org/wildfire25-tw #scienceproject #sciencefair #scienceteacher #machinelearning

It’s #WorldSpaceWeek! 🚀 The 2025 theme, Living in Space, highlights the challenge of making space habitable. Students can use #arduino to build and test a clinostat to see how plants might grow in microgravity. Project: sbgo.org/wswclinostat25… #scienceproject #STEM #scichat

Love seeing kids taught the Biblical truth of flat earth and the firmament dome. 😁 Repost from @thefittestflatearther •The best darn #scienceproject I’ve ever seen 😁
DIY seed paper ghosts for Halloween are spooky, sustainable #STEM fun! Upcycle old paper to make seed cards that can be shared and then planted! sbgo.org/seedpaper25-tw #scienceproject #sciencefair #scienceteacher #Halloween #scichat

There are many alternatives to plastic, and one popular product is beeswax wraps. Are beeswax wraps a suitable replacement for plastic wrap? | sciencebuddies.org/science-fair-p… via @ScienceBuddies #ScienceProject #SciEd #STEM #SciChat
Can you find microbes today that could have survived the different pH conditions of the early Earth's oceans? Explore with this astrobiology project. sbgo.org/modernmicrobes… #STEM #scienceproject #spacescience #microbiology #scichat

Are you working with Arduino and running into a problem? This Arduino Troubleshooting Guide helps students troubleshoot #STEM projects with #arduino. sbgo.org/arduinotrouble… #scienceproject #sciencefair #scienceteacher

Can AI and machine learning models be used to predict wildfires? Students can experiment with the Prophet machine learning model to find out. Directions: sbgo.org/wildfire25-tw #scienceproject #sciencefair #scienceteacher #machinelearning #aiproject

🤣👍Three-way laser home security system #experiment #circuit #scienceproject youtube.com/shorts/GXtdx4C… via @YouTube

youtube.com
YouTube
Three-way laser home security system #experiment #circuit #sciencep...
Many of us use wireless devices, like cell phones, tablets, and laptops, every day. Measure How Wireless Signal Strength Changes with Distance Using a Micro:bit sciencebuddies.org/science-fair-p… via @ScienceBuddies #ScienceProject #STEM #SciEd #SciChat

How is your focus? Learn more about the Wisconsin Card Sorting Test & experiment to see if something as simple as "standing" makes a difference in executive function. Project: sbgo.org/focus25-tw #Neurodiversity #CognitiveScience #scienceproject #sciencefair #scienceteacher

Inspire student curiosity with “color”-focused #STEM projects, from chemical reactions to color separation, biotechnology, plant science, and the physics of light. sbgo.org/color25-tw #scienceproject #scienceteacher #sciencefair

With a Kimchi Chemistry project from Science Buddies, these middle school students turned an interest in food science into a flavorful exploration of chemistry and fermentation for the STEM Fair. sbgo.org/ss-kimchi25-tw #sciencefair #scienceproject #scienceteacher

Good to see that some things never change, like $RUN burning another $(865)M in the latest quarter. #ScienceProject

Three-way laser home security system #experiment #circuit #scienceproject youtube.com/shorts/GXtdx4C… عبر @YouTube

youtube.com
YouTube
Three-way laser home security system #experiment #circuit #sciencep...
November is #DiabetesAwarenessMonth - Students can explore the science behind blood glucose, insulin, and biomedical innovation with hands-on #STEM projects that connect biology, health, and engineering. sbgo.org/diabetes25-tw #scienceproject #scienceteacher #sciencefair

With a Kimchi Chemistry project from Science Buddies, these middle school students turned an interest in food science into a flavorful exploration of chemistry and fermentation for the STEM Fair. sbgo.org/ss-kimchi25-tw #sciencefair #scienceproject #scienceteacher

Slaying the #scienceproject game with #MusicalGlasses, explained here by Harris V. And for all you @espn fans, see if you can recognize the song Harris plays using different volumes of water to impact pitch, which he measured using an app on his phone! 🤗



𝐒𝐜𝐢𝐞𝐧𝐜𝐞 𝐄𝐱𝐡𝐢𝐛𝐢𝐭𝐢𝐨𝐧 𝐡𝐨𝐬𝐭𝐞𝐝 𝐛𝐲 𝐜𝐥𝐮𝐬𝐭𝐞𝐫 𝐄𝐚𝐬𝐭 𝐚𝐧𝐝 𝐖𝐞𝐬𝐭. #ScienceExhibition #scienceproject #schoolactivities #BaithakSchoolNetwork #SupportBaithakSchools




China technology जो दिन में पृथ्वी से चाँद की दूरी मापी हैं जो साइंस एंड टेक्नोलॉजी me नयी क्रांतिकारी उपलब्धियां मानी जा रहीं है #scienceproject #China #technologydevelopment

How is your focus? Learn more about the Wisconsin Card Sorting Test & experiment to see if something as simple as "standing" makes a difference in executive function. Project: sbgo.org/focus25-tw #Neurodiversity #CognitiveScience #scienceproject #sciencefair #scienceteacher

November is #DiabetesAwarenessMonth - Students can explore the science behind blood glucose, insulin, and biomedical innovation with hands-on #STEM projects that connect biology, health, and engineering. sbgo.org/diabetes25-tw #scienceproject #scienceteacher #sciencefair

New student #AI #STEM project: Use the Prophet machine learning model to predict areas of wildfire susceptibility and intensity. Directions: sbgo.org/wildfire25-tw #scienceproject #sciencefair #scienceteacher #machinelearning

Can you find microbes today that could have survived the different pH conditions of the early Earth's oceans? Explore with this astrobiology project. sbgo.org/modernmicrobes… #STEM #scienceproject #spacescience #microbiology #scichat
بیٹھک اسکول نیٹ ورک کے تحت کُل پاکستان سطح پر جاری سائنسی نمائش میں کلسٹر حیدرآباد،گوادر اور بن قاسم نے بھی مختلف پراجیکٹس بنا کر حصہ لیا. #ScienceExhibition #scienceproject #schoolactivities #BaithakSchoolNetwork #SupportBaithakSchools




Inspire student curiosity with “color”-focused #STEM projects, from chemical reactions to color separation, biotechnology, plant science, and the physics of light. sbgo.org/color25-tw #scienceproject #scienceteacher #sciencefair

Are you working with Arduino and running into a problem? This Arduino Troubleshooting Guide helps students troubleshoot #STEM projects with #arduino. sbgo.org/arduinotrouble… #scienceproject #sciencefair #scienceteacher

Ahh, Sunrun you never disappoint. How to turn NEGATIVE FCF of $(1,050)M in the 4Q into positive “Cash Generation” of $34M! $RUN #ScienceProject



What microbes that exist today could have survived the pH conditions of early Earth? Investigate with microorganisms from a local water source in this student #microbiology project. sbgo.org/modernmicrobes… #STEM #scienceproject #spacescience #scienceteacher

DIY seed paper ghosts for Halloween are spooky, sustainable #STEM fun! Upcycle old paper to make seed cards that can be shared and then planted! sbgo.org/seedpaper25-tw #scienceproject #sciencefair #scienceteacher #Halloween #scichat

Fifth grade students make their own first aid kit to finish the Science project about Health Habits and First Aid. 🚑 #HealthHabits #FirstAid #ScienceProject #escucha @feye_enred



What happens when a collision in space leads to a chain reaction of more collisions? Student #STEM project: “Simulating The Kessler Syndrome: How Satellite Collisions Could Spiral Out of Control.” sbgo.org/kessler25-tw #worldspaceweek #scienceproject #scienceteacher #scichat

Something went wrong.
Something went wrong.
United States Trends
- 1. #SmackDown 37.5K posts
- 2. Mamdani 387K posts
- 3. Reed Sheppard 1,761 posts
- 4. Marjorie Taylor Greene 45.7K posts
- 5. Syla Swords 2,294 posts
- 6. Azzi 13.2K posts
- 7. #BostonBlue 3,219 posts
- 8. #OPLive 1,789 posts
- 9. Aiyuk 5,412 posts
- 10. UConn 6,559 posts
- 11. Derik Queen 3,286 posts
- 12. Melo 15.7K posts
- 13. Derrick White N/A
- 14. Norvell 1,273 posts
- 15. Zohran 186K posts
- 16. Todd 24.3K posts
- 17. Kevin Love 1,152 posts
- 18. Duce 1,136 posts
- 19. Sarah Strong 4,019 posts
- 20. #RissaHatchDay25 10.2K posts






























